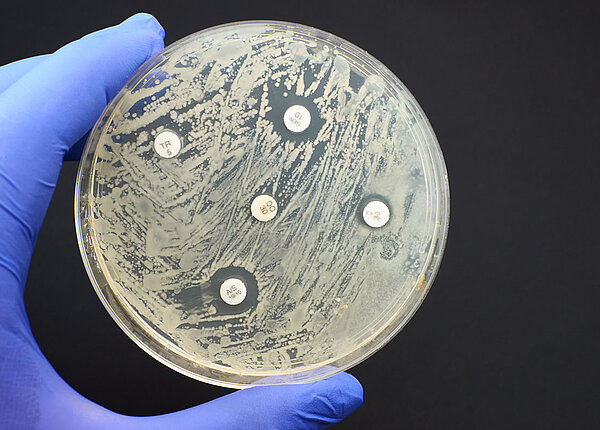
Fachmedium für PTA diepta.de

Un'antiparticella è una particella che corrisponde per massa a una delle normali particelle, ma è caratterizzata da alcuni numeri quantici opposti, come la carica elettrica o il numero barionico. Ad esempio il positrone, antiparticella dell'elettrone, ha la sua stessa massa, ma carica elettrica opposta. Esiste un'antiparticella per ognuna delle particelle conosciute; l'insieme delle antiparticelle compone l'antimateria. Alcune particelle, come il fotone, hanno carica elettrica e altri numeri quantici tutti nulli: in questo caso particella e antiparticella coincidono.
Le antiparticelle possono essere prodotte in decadimenti radioattivi o tramite interazioni tra particelle, come ad esempio nelle reazioni nucleari, nell'interazione dei raggi cosmici con i componenti delle molecole presenti in atmosfera o in interazioni prodotte da acceleratori di particelle. Esse interagiscono molto velocemente con le particelle con un fenomeno chiamato annichilazione, nel quale la massa della particella e dell'antiparticella si trasforma in energia elettromagnetica. Per questo motivo, quando create in laboratorio, le antiparticelle, anche se stabili, restano osservabili solo per tempi molto brevi prima di annichilarsi con le particelle del mezzo in cui sono prodotte. Esiste anche la possibilità che particelle e antiparticelle formino per tempi brevissimi stati legati chiamati onii, come particelle (i mesoni) o atomi esotici (ad esempio il positronio).
Storia
Nel 1928 Paul Dirac realizza una trattazione della meccanica quantistica che, estendendo l'equazione di Schrödinger, tiene conto della teoria della relatività ristretta. La nuova equazione che ne deriva, che prenderà il nome di equazione di Dirac, prevede come soluzioni anche elettroni a energia negativa. Nell'intento di attribuire a questi stati un significato fisico, Dirac elabora un modello che interpreta il vuoto (stato di minima energia) come completamente occupato da un "mare" di elettroni con energia negativa (mare di Dirac); questi elettroni possono talvolta subire salti quantici lasciando nel mare a energia negativa "buche" o "lacune" che rappresentano un nuovo tipo di particella virtuale. Dopo varie ipotesi, nel 1931 Dirac conclude che le nuove particelle previste dal suo modello hanno le stesse caratteristiche degli elettroni, ma carica elettrica opposta (ossia positiva) e per questo chiamate positroni. Nel 1932 Carl David Anderson individua tra i sottoprodotti delle collisioni dei raggi cosmici i positroni previsti da Dirac, che si dimostrano particelle reali.
Il modello di Dirac, affetto da alcune incongruenze, viene poi superato dalla trattazione dell'antimateria nell'ambito della teoria quantistica dei campi. Nel 1955 a Berkeley Emilio Segrè e Owen Chamberlain scoprono l'antiprotone e per la scoperta vincono il Premio Nobel per la fisica nel 1959.
Nomenclatura
Il simbolo usato per indicare un'antiparticella, di solito, è lo stesso usato per la particella corrispondente, ma con una barra di sovrascrittura. Ad esempio, il protone è indicato con una "p", e l'antiprotone è indicato da (una "p" con una barra posta in cima). In alternativa, quando una particella è indicata con la sua carica, l'antiparticella viene indicata con la carica opposta (es.: ed rappresentano rispettivamente positrone ed elettrone). Nel primo caso il simbolo è usato in analogia a quello del complesso coniugato di un numero complesso, dato che l'inversione di carica di una particella, che la trasforma nella sua antiparticella, è legata alla coniugazione della sua funzione d'onda.
Annichilazione particella-antiparticella
Se la particella e l'antiparticella sono nello stato quantico appropriato, allora queste possono annichilarsi l'un l'altra e produrre altre particelle. Reazioni come l'annichilazione in due fotoni di una coppia elettrone-positrone:
sono un esempio di questo fenomeno. L'annichilazione in un singolo fotone di una coppia elettrone-positrone non è possibile nello spazio libero perché è impossibile conservare energia e momento insieme in questo processo. La reazione inversa (nello spazio libero, senza nucleo atomico) è anche impossibile per la stessa ragione. Tuttavia in un campo di Coulomb di un nucleo l'invarianza traslazionale è rotta e può occorrere una annichilazione in un singolo fotone.Nella teoria dei campi questo processo è consentito solo come stato quantico intermedio per tempi abbastanza piccoli perché la violazione della conservazione rientri nel principio di indeterminazione. Questo apre la via per la produzione e l'annichilazione di coppie di particelle virtuali in cui uno stato quantico a una particella può fluttuare in due particelle e ritornare quindi allo stato originario. Questi processi sono importanti nello stato di vuoto e nella rinormalizzazione di una teoria di campo.
Note
Bibliografia
- Feynman, R.P. "The reason for antiparticles", in The 1986 Dirac memorial lectures, R.P. Feynman and S. Weinberg. Cambridge University Press, 1987. ISBN 0-521-34000-4.
- Weinberg, Steven. The quantum theory of fields, Volume 1: Foundations. Cambridge University Press, 1995. ISBN 0-521-55001-7.
- Feynman, R.P., QED: La strana teoria della luce e della materia, Adelphi, ISBN 88-459-0719-8
- Claude Cohen-Tannoudji, Jacques Dupont-Roc, Gilbert Grynberg, Photons and Atoms: Introduction to Quantum Electrodynamics (John Wiley & Sons 1997) ISBN 0-471-18433-0
- Jauch, J. M., F. Rohrlich, F., The Theory of Photons and Electrons (Springer-Verlag, 1980)
- Feynman, R.P. Quantum Electrodynamics (Perseus Publishing, 1998) ISBN 0-201-36075-6
Voci correlate
- Antimateria
- Modello standard
- Scattering
- Diagramma di Feynman
- Propagatore
- Fotoni
- Bosone (fisica)
- Bosoni vettore
- Bosoni vettori assiali
- Elettrodinamica quantistica
- Lista delle particelle
Altri progetti
- Wikimedia Commons contiene immagini o altri file su antiparticella
Collegamenti esterni
- antiparticella, su Treccani.it – Enciclopedie on line, Istituto dell'Enciclopedia Italiana.
- Marcello Ciafaloni Complementi di Fisica Teorica: Introduzione alla teoria dei campi (Università di Firenze)
- Roberto Casalbuoni Elettrodinamica Quantistica (Università di Firenze)
- Roberto Casalbuoni Teoria dei campi: Storia e Introduzione (Università di Firenze, 2001)